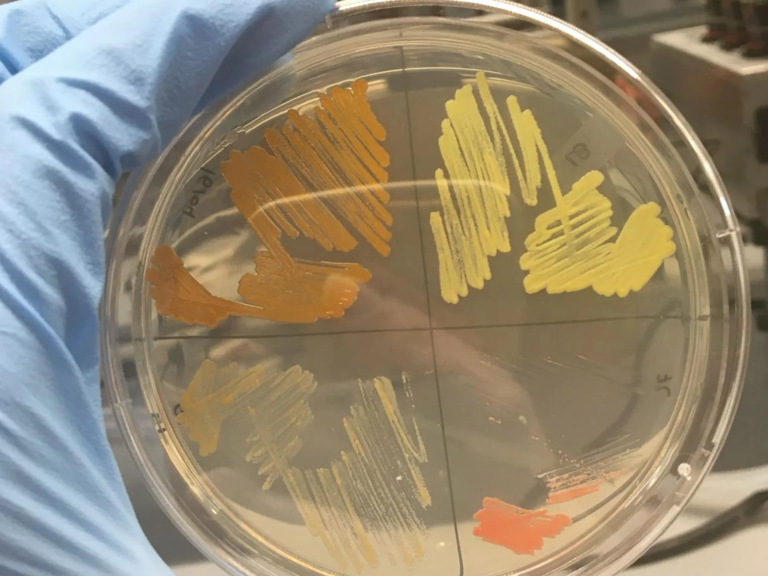
A person holding a petri dish

Microorganisms
Microorganisms
Harvard experts are exploring how we can work with, defend against, and harness the capabilities of the estimated five nonillion microbes living on Earth today.
Exploring the world inside us
The human body contains trillions of microorganisms, with the largest numbers found in the intestines. Scientists are just beginning to discover all the ways these microbes interact with our bodily functions.

Common diseases
A large-scale study demonstrates a clear association between specific microbial species in the gut, certain foods, and the risk of diabetes, heart disease, and obesity.
Common diseasesCancer
Unravelling how microbes enhance the body’s response to cancer treatments
Vaginal health
Sharing research to help people understand an overlooked microbiome
Dental health
Exploring how tongue microbes are very different from teeth microbes
Exercise
Understanding how a microbe in elite athletes helps exercise performance in mice
Happiness
Detailing the links between specific gut bacteria and positive emotions
Introducing
Sphingomonas solaris
A new bacterium found on solar panels at the Arnold Arboretum.
Supporting the world around us
Scientists are utilizing microbes to help advance sustainability and turn the tide on climate change.
We envision a truly circular economy in which microbes convert gases to commodity products—from plastics to food to clothes, etc.”Shannon Nangle
Research associate and co-leader of the Circe project alongside Research Scientist Marika Ziesack (right).

Plastic eaters
Plastic-eating microbes capable of degrading multiple types of plastics could help reduce global waste and mitigate pollution.
Climate coolers
Scientists have found that coastal mud bacteria are able to produce climate cooling gases that reflect sunlight away from Earth.
Carbon captors
Researchers are exploring reductions in global warming by genetically turbocharging an oceanic bacterium’s natural ability to pull carbon dioxide from the atmosphere.
Single-cell and ready to mingle
Harvard experts are uncovering bacterial mysteries, exploring their medical potential, and learning how a fungus can control an animal’s behavior.

Controlling the mind

Peering into the cell

Sharing with your baby

Sneaking around the body

Treating pain

Teaming up to fight bacteria

Following the breadcrumbs
Become more cultured
Learn from Harvard experts how to grow yeast and bacteria for food and science.

Fermentation
In the kitchen
Learn about the history and science behind cultured consumables, and explore the roles that microbes play in the production, preservation, and enhancement of foods and drinks.

incubation
In the lab
Learn more about the structure of microbes, the different phases of growth, how they reproduce, and what byproducts they create.
You may also like
